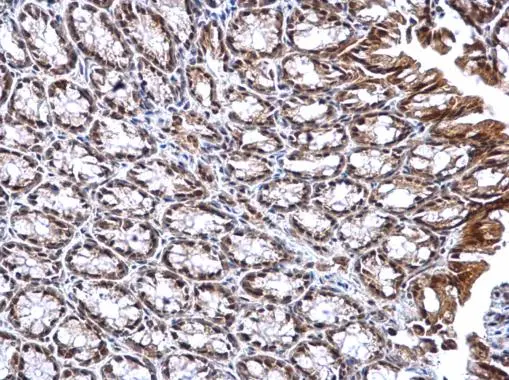
DNTTIP1 antibody detects DNTTIP1 protein at nucleus on mouse colon by immunohistochemical analysis. Sample: Paraffin-embedded mouse colon. DNTTIP1 antibody (GTX120392) dilution: 1:1000. 
 Antigen Retrieval: Trilogy? (EDTA based, pH 8.0) buffer, 15min

DNTTIP1 antibody detects DNTTIP1 protein at nucleus on mouse hind brain by immunohistochemical analysis. Sample: Paraffin-embedded mouse hind brain. DNTTIP1 antibody (GTX120392) dilution: 1:1000.
Antigen Retrieval: Trilogy? (EDTA based, pH 8.0) buffer, 15min
DNTTIP1 antibody
GTX120392
ApplicationsImmunoHistoChemistry, ImmunoHistoChemistry Paraffin
Product group Antibodies
ReactivityHuman, Mouse, Rat
TargetDNTTIP1
Overview
- SupplierGeneTex
- Product NameDNTTIP1 antibody
- Delivery Days Customer9
- Application Supplier NoteIHC-P: 1:100-1:1000. *Optimal dilutions/concentrations should be determined by the researcher.Not tested in other applications.
- ApplicationsImmunoHistoChemistry, ImmunoHistoChemistry Paraffin
- CertificationResearch Use Only
- ClonalityPolyclonal
- Concentration1 mg/ml
- ConjugateUnconjugated
- Gene ID116092
- Target nameDNTTIP1
- Target descriptiondeoxynucleotidyltransferase terminal interacting protein 1
- Target synonymsC20orf167, Tdif1, dJ447F3.4, deoxynucleotidyltransferase terminal-interacting protein 1, TdT binding protein, tdT-interacting factor 1, terminal deoxynucleotidyltransferase-interacting factor 1
- HostRabbit
- IsotypeIgG
- Protein IDQ9H147
- Protein NameDeoxynucleotidyltransferase terminal-interacting protein 1
- Scientific DescriptionDNTTIP1 binds DNA and enhances the activity of terminal deoxynucleotidyltransferase (TDT, or DNTT; MIM 187410), a DNA polymerase that catalyzes the polymerization of DNA in the absence of a DNA template (Yamashita et al., 2001 [PubMed 11473582]).[supplied by OMIM]
- ReactivityHuman, Mouse, Rat
- Storage Instruction-20°C or -80°C,2°C to 8°C
- UNSPSC12352203

![ICC/IF analysis of COS7 cells transiently transfected with DNTTIP1 plasmid using GTX84603 DNTTIP1 antibody [1E2].](https://www.genetex.com/upload/website/prouct_img/normal/GTX84603/GTX84603_1149_ICCIF_w_23061420_774.webp)

